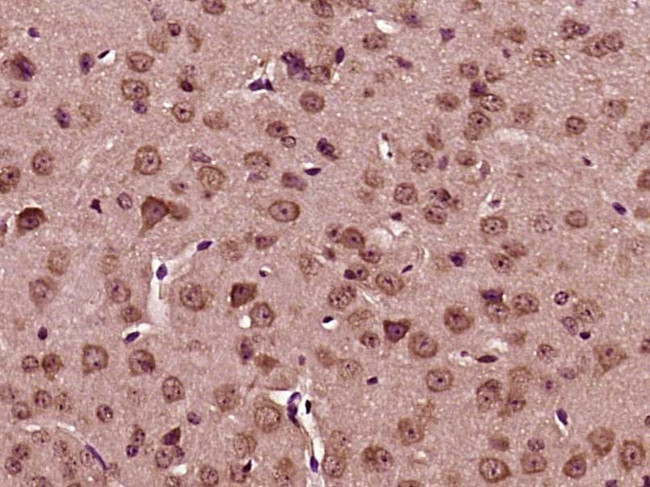
BRAF35 Antibody in Immunohistochemistry (Paraffin) (IHC (P))

Search
Bioss
BRAF35 Polyclonal Antibody
{{$productOrderCtrl.translations['antibody.pdp.commerceCard.promotion.promotions']}}
{{$productOrderCtrl.translations['antibody.pdp.commerceCard.promotion.viewpromo']}}
{{$productOrderCtrl.translations['antibody.pdp.commerceCard.promotion.promocode']}}: {{promo.promoCode}} {{promo.promoTitle}} {{promo.promoDescription}}. {{$productOrderCtrl.translations['antibody.pdp.commerceCard.promotion.learnmore']}}
图: 1 / 1
BRAF35 Antibody (BS-12883R) in IHC (P)

产品信息
BS-12883R
种属反应
宿主/亚型
分类
类型
抗原
偶联物
形式
浓度
规格
纯化类型
保存液
内含物
保存条件
运输条件
靶标信息
Required for correct progression through G2 phase of the cell cycle and entry into mitosis. Required for RCOR1/CoREST mediated repression of neuronal specific gene promoters.
仅用于科研。不用于诊断过程。未经明确授权不得转售。
篇参考文献 (0)
生物信息学
蛋白别名: 94 kDa B-raf protein; B-Raf proto-oncogene serine/threonine-protein kinase (p94); B-Raf serine/threonine-protein; BRCA2-associated factor 35; FLJ26127; high mobility group 20 B; high mobility group protein 20 B; HMG box domain containing 2; HMG box-containing protein 20B; HMG domain-containing protein 2; HMG domain-containing protein HMGX2; HMG-box containing protein; HMG20B; murine sarcoma viral (v-raf) oncogene homolog B1; p94; Proto-oncogene B-Raf; serine/threonine protein kinase; Serine/threonine-protein kinase B-raf; SMARCE1-related protein; SMARCE1r; Sox-like transcriptional factor; Structural DNA-binding protein BRAF35; SWI/SNF-related matrix-associated actin-dependent regulator of chromatin subfamily E member 1-related; SWI/SNF-related matrix-associated actin-dependent regulator of chromatin subfamily E, member 1-related; unnamed protein product; v-raf murine sarcoma viral oncogene homolog B; v-Raf murine sarcoma viral oncogene homolog B1
基因别名: 9930012E13Rik; AA120551; AA387315; AA473386; AW610687; B-raf; B-RAF1; BRAF; BRAF-1; Braf-2; BRAF1; Braf2; BRAF25; BRAF35; C230098H17; C87398; D6Ertd631e; HMG20B; HMGX2; HMGXB2; NS7; PP7706; pp8857; RAFB1; SMARCE1R; SOXL
UniProt ID: (Human) P15056, (Mouse) P28028, (Human) Q9P0W2, (Mouse) Q9Z104
Entrez Gene ID: (Human) 673, (Rat) 114486, (Mouse) 109880, (Human) 10362, (Rat) 362825, (Mouse) 15353